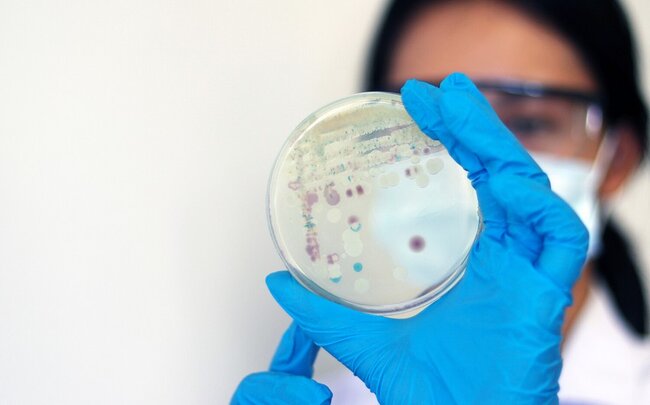
ABŞ-də "ət yeyən" bakteriyaya yoluxma hallarının sayı artıb

ABŞ-də "ət yeyən" bakteriyaya yoluxma hallarının sayı artıb
 ABŞ-nin sahilyanı bölgələrində "ət yeyən" kimi təsnif edilən "Vibrio vulnificus" bakteriyasına yoluxma hallarının sayı artıb.
ABŞ-nin sahilyanı bölgələrində "ət yeyən" kimi təsnif edilən "Vibrio vulnificus" bakteriyasına yoluxma hallarının sayı artıb.
"Report" xəbər verir ki, bu barədə "Tribuna" məlumat yayıb.
ABŞ Xəstəliklərə Nəzarət və Qarşısının Alınması Mərkəzlərinin məlumatına görə, bakteriya artıq Florida və Luiziana da daxil olmaqla 11 ştata yayılıb. Bəziləri ölümlə nəticələnən onlarla hadisə qeydə alınıb.
Hər beş yoluxma hadisəsindən biri 48 saat ərzində ölümlə nəticələnir.
Bakteriyalar isti duzlu suda yaşayır. Bədənə zəif bişmiş dəniz məhsulları və hətta kiçik açıq yara vasitəsilə daxil ola bilər. İnfeksiyanın ilk əlamətləri ishal, qusma və dəridə qabarcıqlardır.
Sonxeber.az
 Telegramda izləyin
Telegramda izləyin
Dünyada Baxılıb: 461 Tarix: 24 avqust 2025
Şikayətiniz varsa Whatsapp: 077 7125666
Facebookda Paylaş
Qurban kəsimi rəsmən qadağan edildi - Bu ölkədə
Qurban bayramına sayılı günlər qalmış bəzi ölkələrdə dini qaydalara uyğun qurban kəsiminə tətbiq edilən məhdudiyyətlər yenidən gündəmə gəlib. -a istinadən xəbər verir ki, heyvan rifahı qanunları, ictimai asayiş və iqtisadi səbəblərlə müxtəlif tətbiqlərin həyata keçirildiyi bəzi ölkələrdə qurban kəsim
23 may"Epidemiya o bölgəyə yayılsa, fəlakət olacaq" - Fotolar
Ebola epidemiyası Konqo Demokratik Respublikasınin şərq bölgələrində yayılmaqda davam edir. Xəstəliyin silahlı qrupların nəzarətində olan ərazilərə çatması narahatlıqları artırıb. "Qafqazinfo" AFP-yə istinadən xəbər verir ki, Ümumdünya Səhiyyə Təşkilatı tərəfindən fövqəladə vəziyyət kimi qiymətləndirilə
22 mayKİV: ABŞ yaxın günlərdə İrana hücuma hazırlaşır
ABŞ Administrasiyası, xüsusən də Pentaqon və kəşfiyyat orqanlarının nümayəndələri qarşıdakı üç gün ərzində İrana qarşı hərbi əməliyyatların bərpa olunmasına hazırlıq görürlər. xəbər verir ki, bu barədə CBS telekanalı mənbələrinə istinadən məlumat yayıb. Məlumata görə, bəzi ABŞ hərbi və kəşfiyyat rəsmilər
23 may"Green card" qaydalarında dəyişiklik edildi
ABŞ "Green card" qaydalarında dəyişikliklər edib. xəbər verir ki, bununla bağlı ABŞ-nin Vətəndaşlıq və İmmiqrasiya Xidməti (USCIS) məlumat yayıb. Belə ki, artıq ABŞ ərazisində olan zaman "Green card" üçün müraciət etmək mümkün olmayacaq. Tramp administrasiyası bu ölkədə olan və "Gree
23 maySuda üzə bildiyi deyilmişdi, göldə batdı - Fotolar
ABŞ-də "Tesla Cybertruck" elektromobili ilə Qreypvayn gölünə daxil olan sürücü həbs olunub. "Qafqazinfo" "Electrek" nəşrinə istinadən xəbər verir ki, hadisə Texas ştatında baş verib. Belə ki, yeni aldığı elektromobilin amfibiya rejimini ("Wade Mode") sınaqdan keçirmə
21 may ABŞ-nin sahilyanı bölgələrində "ət yeyən" kimi təsnif edilən "Vibrio vulnificus" bakteriyasına yoluxma hallarının sayı artıb.
ABŞ-nin sahilyanı bölgələrində "ət yeyən" kimi təsnif edilən "Vibrio vulnificus" bakteriyasına yoluxma hallarının sayı artıb. Telegramda izləyin
Telegramda izləyin












 Ətin qiyməti 39 manata QALXDI
Ətin qiyməti 39 manata QALXDI Ardıcıl 5 gün iş olmayacaq
Ardıcıl 5 gün iş olmayacaq Mayın 25-də QAZ OLMAYACAQ
Mayın 25-də QAZ OLMAYACAQ Bu universitetin qapısı möhürləndi, tələbələr ayağa qalxdı
Bu universitetin qapısı möhürləndi, tələbələr ayağa qalxdı Əli Əsədov QƏRAR İMZALADI - Bu şəxslərə hər ay 100 MANAT VERİLƏCƏK
Əli Əsədov QƏRAR İMZALADI - Bu şəxslərə hər ay 100 MANAT VERİLƏCƏK 12 il əvvəl 9 yaşlı məktəblini xilas edən - Dəyanət qəfil öldü
12 il əvvəl 9 yaşlı məktəblini xilas edən - Dəyanət qəfil öldü Vəzifəli şəxs vəfat etdi - Foto
Vəzifəli şəxs vəfat etdi - Foto Xalq artisti: "Bütün qazancım həkimlərə gedir, zülüm çəkirəm"
Xalq artisti: "Bütün qazancım həkimlərə gedir, zülüm çəkirəm" İslam Rzayev haqda - Yeni qərar
İslam Rzayev haqda - Yeni qərar Sabiq deputat Türkiyədə vəfat etdi
Sabiq deputat Türkiyədə vəfat etdi Badımcanı belə bişirin, dadı ətdən daha ləzzətli olur
Badımcanı belə bişirin, dadı ətdən daha ləzzətli olur Bu şəxsləri işə götürənlər cərimə ediləcək
Bu şəxsləri işə götürənlər cərimə ediləcək Hər yaşda risk var: Ürək çatışmazlığını göstərən 4 kritik siqnal
Hər yaşda risk var: Ürək çatışmazlığını göstərən 4 kritik siqnal Məşhur müğənninin son görüntüsü sosial mediada viral oldu - FOTO
Məşhur müğənninin son görüntüsü sosial mediada viral oldu - FOTO